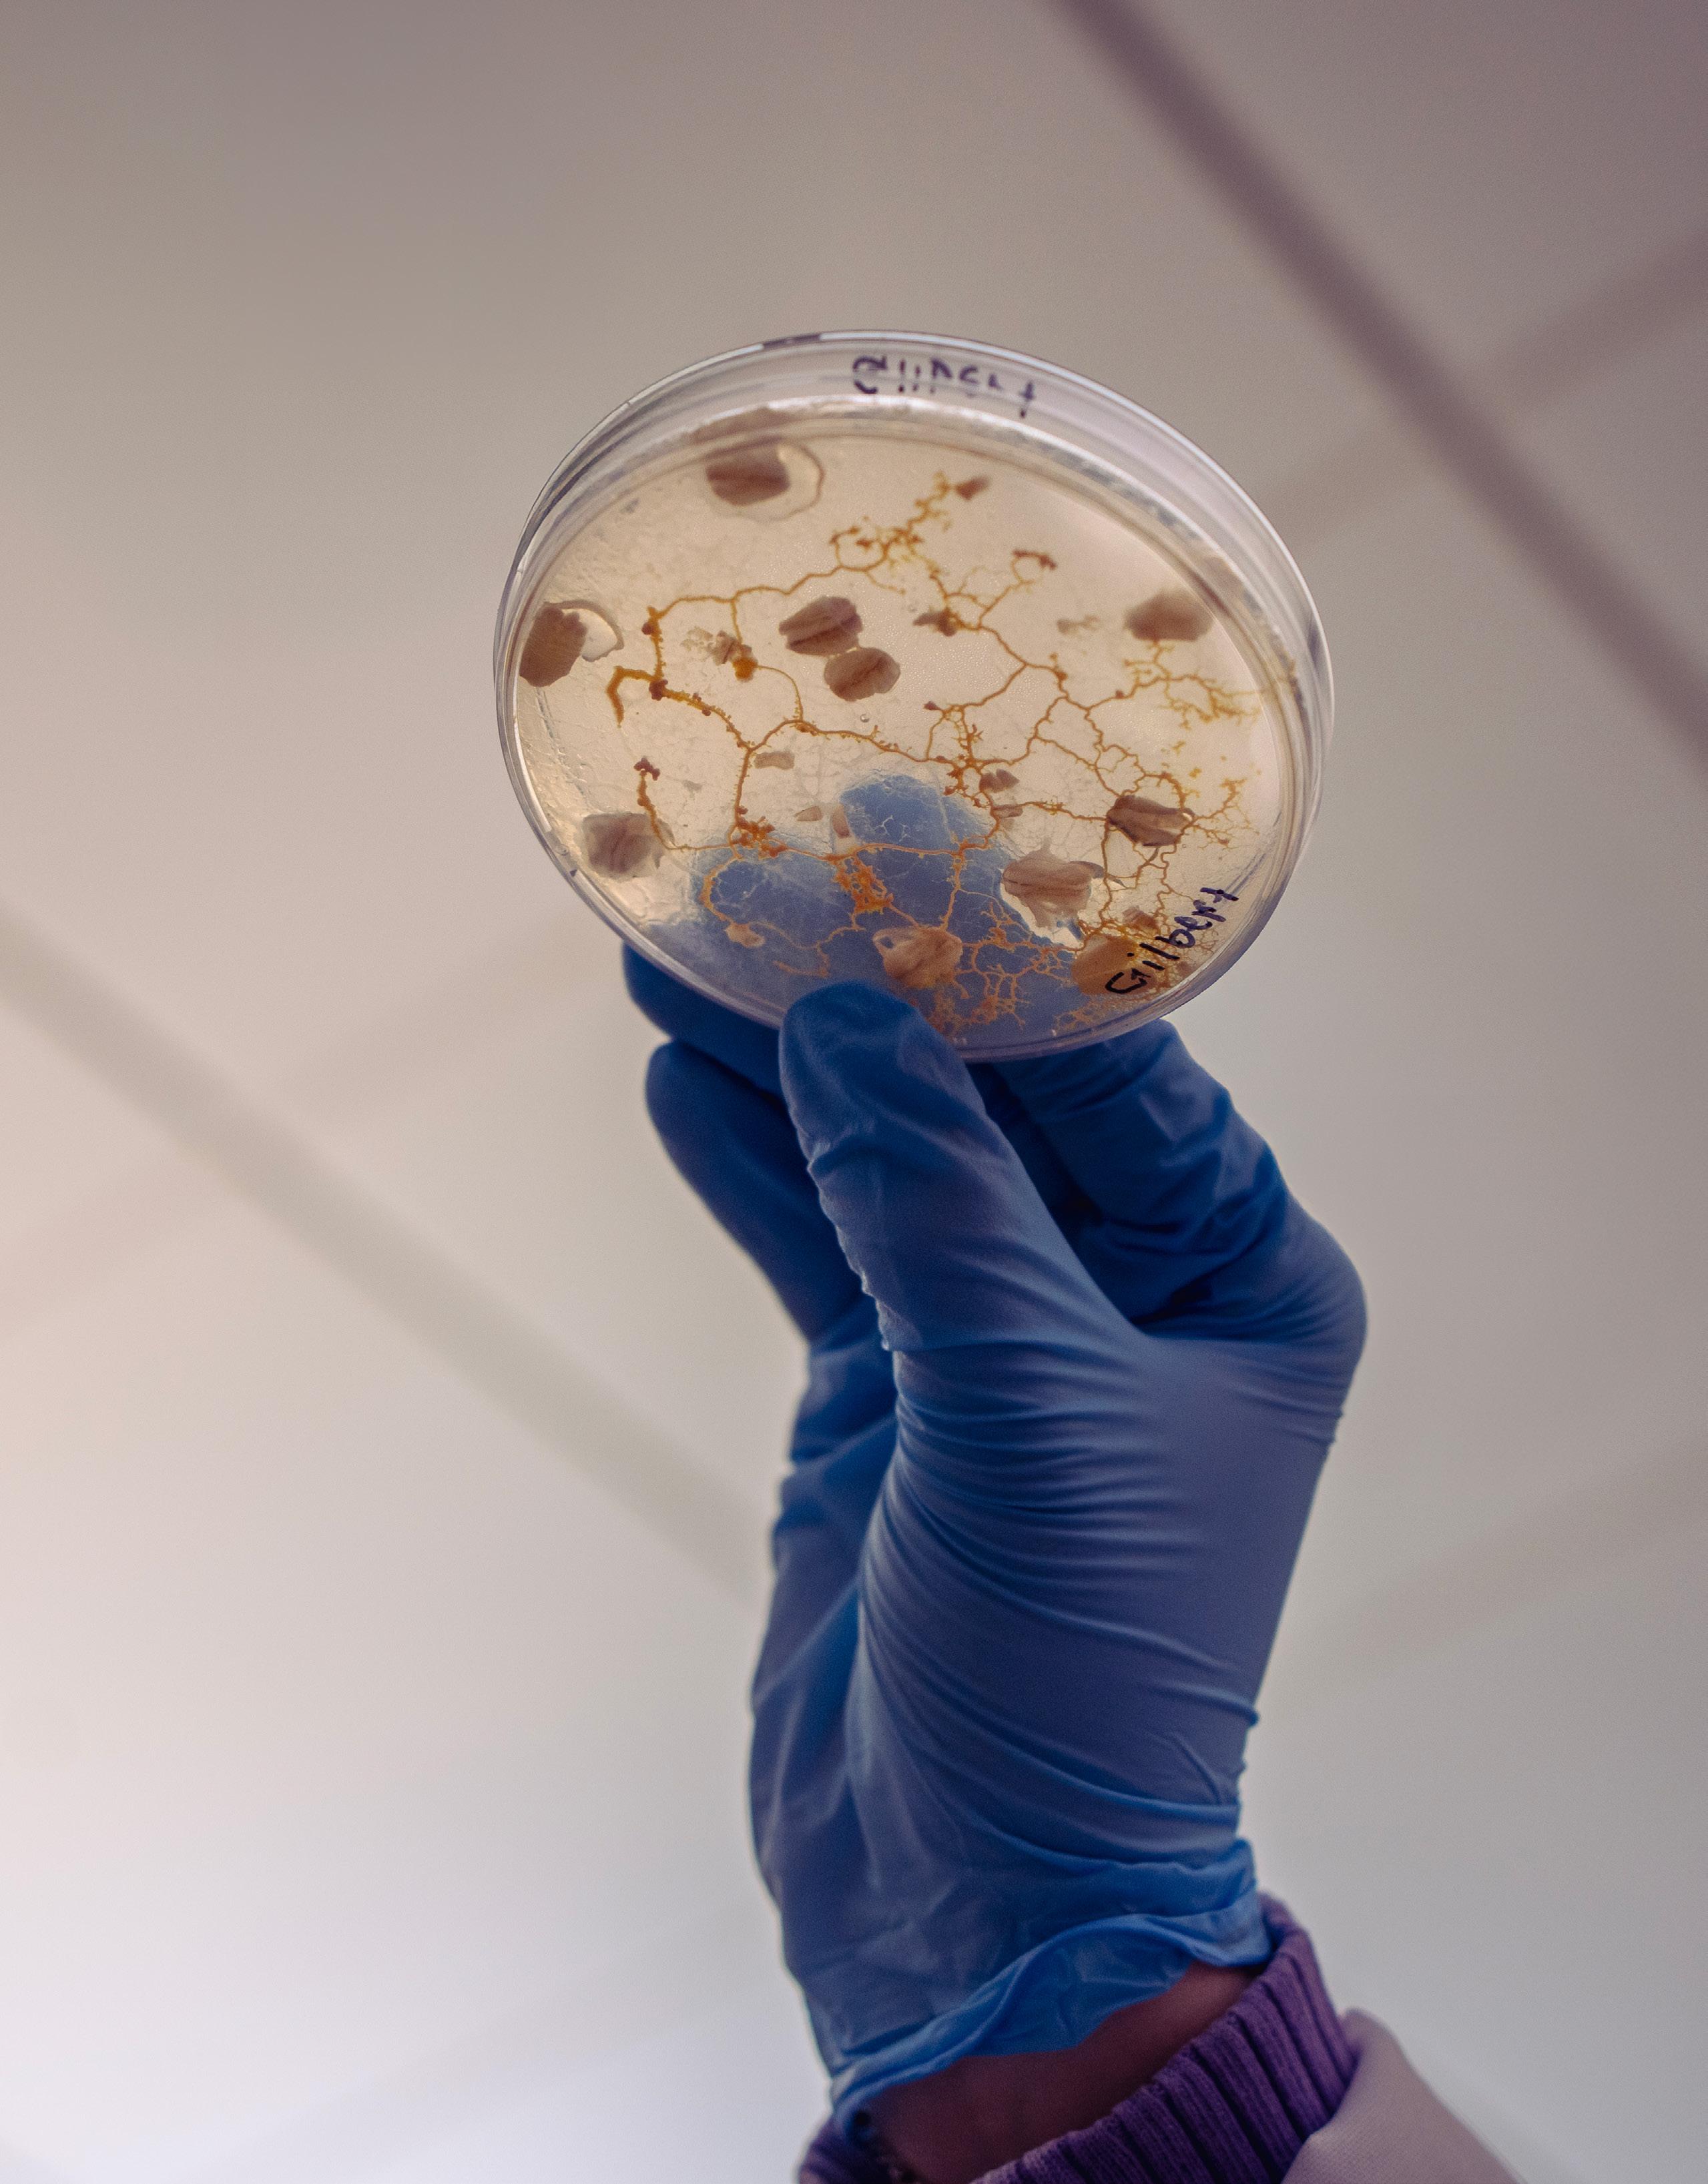
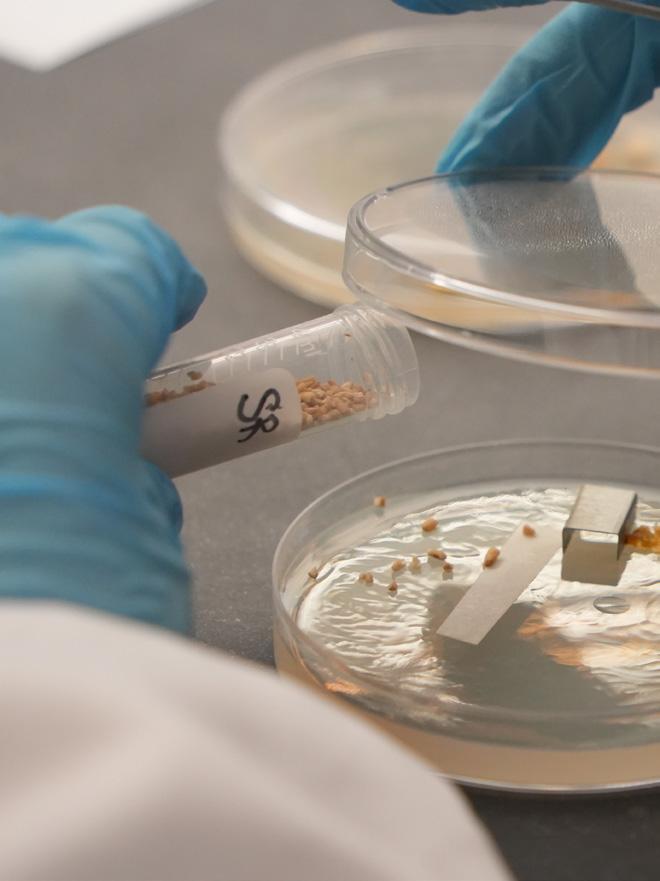

![]()






a CrossDisciplinary Experiment Into a Movement


10 Listening First, Leading Forward
Chancellor Bryan Renfro, PhD, is listening closely, showing up often, and shaping what comes next at EICC.

14 Where Wonder Takes Root
A new era begins at the Bickelhaupt Arboretum.

18 The River Only Goes One Direction
How one instructor’s 2,552-mile paddle reshaped the way he sees the world — and the way he shows up for his students.
04 Next is Now: The Comeback Issue
A bold new brand, a revived magazine, and an EICC ready for what’s next.
09 From the Oil Field to the Classroom
A Marine veteran returns to school at 47, turning global experience into a new start in agribusiness.
12 Chris Bolin — Where He Is Now, and Why From recovery to engineering, Bolin’s EICC start helped him build the structure to thrive at Milwaukee School of Engineering.
16 Built Here, Teaching Here
A former Culinary Career Academy student returns to EICC — this time as an instructor, helping shape the next generation of chefs.
20 AI Is Here — And EICC Is Preparing the Workforce
A new program will create a direct path into emerging tech careers close to home.
21 Built by Industry, Backed by Education Riverbend FAME pairs employers with EICC training to meet real workforce demand.
22 Community College Month Opens Doors
Across Eastern Iowa
More than 40 free classes. One month of thanks. Endless opportunities to explore.

A brainless slime mold’s surprising “choices” ignite student curiosity and inspire a cross-disciplinary project built around real-time discovery.
Welcome to the newest chapter of EICC Magazine, formerly THE Community’s College Magazine. Thank you for opening these pages. Whether you have been with us for years or are discovering this publication for the first time, we are glad you are here. This magazine is more than a relaunch. It is a reflection of who we are and where we are headed as Eastern Iowa Community Colleges.
Across our campuses, there is real momentum. Classrooms are filled with curiosity. Faculty and staff are finding new ways to support students. Partnerships are expanding. Students are setting bold goals and taking meaningful steps toward their futures. We created this space to share those stories in a way that feels authentic, personal, and worth celebrating.
Inside this issue, you will meet our new chancellor, who is listening closely, showing up across campuses, and keeping student success at the center of every conversation about what comes next. You will read about an interdisciplinary learning experience built around something as unexpected as slime mold, a powerful example of the creativity and hands-on discovery happening in our classrooms. You
will also get a closer look at the evolution of our brand identity and the thoughtful collaboration that shaped the refreshed look you now see throughout our work. And you will meet a courageous student who rebuilt his future after addiction, reminding us all what is possible with determination and support.
These stories reflect the heart of EICC. We are resilient. We are innovative. We are communitycentered. And we are focused on opportunity.
We brought this publication back because this moment deserves it. EICC is growing and evolving across our district. We need a space that captures that energy in a way that feels modern, accessible, and unmistakably ours.
Most importantly, it reflects what we believe at our core: students should not have to wait to build their futures. Next is now.
Thank you for being part of our community. We hope this issue leaves you inspired, connected, and excited about what comes next. Welcome back to EICC Magazine.
Johnna Kerres, Associate Director of Marketing and Communications


Dawn Neuses, Strategic Content and Writing Specialist
Griffin Wagner, Marketing Coordinator DESIGNERS


Nathan Klaus, Graphic Artist
Matt Thomas, Graphic Artist



Nicole Harrison, Web and Digital Strategist
Eli Kayser, Marketing Coordinator
It is the policy of Eastern Iowa Community College District not to discriminate in its programs, activities, or employment on the basis of race, color, national origin, sex, disability, age, sexual orientation, gender identity, creed, religion, and actual or potential family, parental or marital status, as required by the Iowa Code §§216.6 and 216.9, Titles VI and VII of the Civil Rights Act of 1964 (42 U.S.C. §§ 2000d and 2000e), the Equal Pay Act of 1973 (29 U.S.C. § 206, et seq.), Title IX (Educational Amendments, 20 U.S.C. §§ 1681-1688), Section 504 (Rehabilitation Act of 1973, 29 U.S.C. § 794), and Title II of the Americans with Disabilities Act (42 U.S.C. § 12101, et seq.). If you have questions or complaints related to compliance with this policy, please contact EICC’s Equal Employment Opportunity Officer/Equity Coordinator, Eastern Iowa Community College District, 101 West Third Street, Davenport, Iowa 52801, 563-336-5222, equity@eicc.edu or the Office for Civil Rights, U.S. Department of Education, Cesar E. Chavez Memorial Building, 1244 Speer Boulevard, Suite 310, Denver, CO 80204-3582, Telephone: 303-844-5695. FAX: 303-844-4303; TDD: 800-877-8339 or Email: OCR.Denver@ed.gov
The
comeback issue: A bold new brand, a revived magazine, and an EICC ready for what’s next.

Every college has defining moments, when the past, present, and future seem to meet all at once, pointing toward a new direction. For Eastern Iowa Community Colleges (EICC), this is one of those moments.
After years of listening, learning, building, and imagining, EICC unveils a fresh chapter. There’s a new look. A new energy. The district’s refreshed identity is a clear expression of who we are and what we stand for. And it’s
been years in the making.
The transformation began in 2023, when EICC fully redesigned the website — our first major step toward modernizing the student experience. It introduced a refreshed brand voice and a clear identity rooted in accessibility, clarity, and warmth. And that redesign was only the start.
Seeking deeper insight, the EICC marketing team partnered with ad agency Epicosity to lead a comprehensive brand study. Month
by month, the process unfolded: research, focus groups, surveys, interviews, brand audits, and creative exploration. Students. Faculty. Staff. Alumni. High school counselors. Community partners. Every voice shaped the direction.
A consistent message emerged: EICC is modern, approachable, supportive, and full of opportunity. Our identity should reflect that potential.
The refined college logo unveiled this year does exactly that.

For the first time, the ‘EI’ gets to stand confidently on its own — unmistakably EICC.






















“Next is Now” reflects the momentum of our district.
It reflects the urgency students feel to build meaningful futures.
It reflects the belief that opportunity shouldn’t wait.
The new logo keeps what mattered: the “EI” with three bars representing Clinton, Muscatine, and Scott, and the Mississippi-inspired curve that connects us all. Everything else has been thoughtfully streamlined. Cleaner geometry. Sharper angles. Typography that feels modern instead of nostalgic. Most importantly, the logo finally works as beautifully at the size of a fingertip on a mobile screen as it does splashed across a building or billboard. For the first time, the “EI” gets to stand confidently on its own — unmistakably EICC, wherever it appears.
And then there’s the mascot.
The selection was a decision shaped
by our community — and one we’re not quite ready to reveal just yet.
With the mascot selected and our visual identity refreshed, there is one final piece that ties everything together, a simple message.
Threading through every aspect of our current design is EICC’s new creative theme: Next is Now.
These three words capture the essence of what students experience when they come to EICC. Their “next” — the career they want, the college they hope to transfer to, the skills they need, the future they’re imagining — begins not years down the road, but the moment they take their first step with us.
For the first time in district history, EICC is introducing a single mascot to represent all campuses and centers. And while the final design is still under wraps, the process behind the choice is something we’re proud to share.
Students, faculty, and staff across the district participated in a fully inclusive, multi-step process, from early brainstorming to the final vote. The result? A mascot chosen by the EICC community, for the EICC community.
And with EICC’s brand and communication approach, our visuals and voice align with the energy happening across classrooms, labs, learning environments, and communities every day.
This brand evolution is a milestone. A fully realized expression of who we’ve become and who we’re determined to be. It connects our campuses. It clarifies our message. It represents the communities we serve and the futures students build here.
EICC’s new identity is confident, clear, modern, and proudly rooted in Eastern Iowa. It brings our story into sharp focus and signals we are unified in purpose, bold in design, and energized for what’s ahead.
We’re saving that surprise for later this spring — when we’ll unveil the final design with plenty of fanfare (and yes, brand-new swag). Until then, just know this: the mascot reflects our spirit, our energy, and our connection to this place.
The countdown is on.

The slime mold didn’t care that it was being watched. In the soft glow of the microbiology lab at EICC’s Scott campus, students in white coats leaned over a row of Petri dishes, whispering predictions the way fans might around a racetrack.
Someone pointed and said, “Look, it’s doing it again.” A vivid yellow webbing pushed itself across a salt barrier it had avoided only days earlier. Now, it was surging toward an oat flake waiting on the other side.
A single-celled organism, brainless and blind, was making a decision.
And in that moment, crowded around a $3 petri dish lined with nutrient-rich agar — a gelatinlike substance used to grow microorganisms — students watched something astonishing unfold. A living system was solving a problem in real time. A behavior. A preference. A choice.
It was the kind of scene no one, least of all the instructors who built the study, expected to become the heart of a project much larger than they imagined.
For years, Psychology Instructor Gary Buckley and Political Science Instructor Eric Carr had been wrestling with the same question. Were they truly teaching their disciplines as sciences, or had their courses fallen into polished but passive routines of lecture, textbook, and exam.
“We were a bit disappointed,” Buckley said. “We felt like we weren’t achieving what we wanted to for our students. That we weren’t focusing on the science of our discipline.”
They talked. Then read. Then listened to hours of research podcasts. They devoured studies on cognition, systems theory, bioelectricity, planaria, collective behavior, and, eventually, an unconventional organism named Physarum polycephalum — a bright yellow slime mold known for its uncanny ability to solve complex problems without a brain.
And one day, they decided they had learned enough. It was time to act.
“We wanted to do this slime mold study no matter what,” Carr said. “We

would’ve self-funded it. It was going to happen whether anyone liked it or not.”
Within days, the campus began saying yes. A study that could’ve stalled on logistics instead caught fire. Leadership backed the study. The biology department offered lab access. Scott Community Colleges’ (SCC) library staff rushed to source timelapse cameras. The SCC Foundation funded supplies. Faculty began asking where their programs might intersect.
“It was like a rainstorm of people who saw the vision,” Buckley said. Students who weren’t in their classes wanted to join. Among them was psychology student Joeanna Moore, whose curiosity quickly made her a lead consultant.
“You can’t take one of Gary Buckley’s classes without hearing about slime mold,” Moore said, laughing. “But seeing it in the lab? Watching how it behaves? That changed everything for me.”
The project launched as a onecredit Honors Study attached to Buckley and Carr’s existing courses. The timeline was eight weeks. The curriculum was written from scratch. Expectations were flexible and, at times, improvised.
They met in the microbiology lab, where most of the students had never set foot before. Some had learning disabilities. Some hadn’t taken a science class in years. All were invited
to function as scientists. Attendance soared.
“We had 100 percent attendance, and the students kept tabs on each other if someone missed a day,” Carr said. “Students named the slime molds. They talked about food preferences. They really grew into a close, committed cohort.”
Students brought in drawings, arrows mapping the organism’s choices, annotated timelines, photos, predictions. No one asked them to do any of it.
“It’s shocking to me how well they developed hypotheses,” Buckley said. “They walked away with an operational understanding of the scientific method because they used it.”
On paper, slime mold is unremarkable. A single cell with no nerves and no brain. Yet it learns.
Students discovered that Physarum avoids salt, so they created salt barriers. At first, the organism retreated. But hunger and adaptation changed the equation. Gradually, the slime mold began to glide over the salt, seeking the food source beyond it. That was interesting. What happened next was astonishing.
Students cut the slime mold into pieces. They found two “experienced” pieces that had already crossed a salt irritant, and one piece that never had. They placed the inexperienced piece between the experienced ones.
Soon, all three crossed the barrier. Somehow the organisms had shared their knowledge.
Theories filled notebooks. Memory. Conditioning. Agency. Cooperation. Students built toothpick bridges to see whether the organisms preferred a less irritating path. They switched lights, changed temperature, added variables, and recorded every shift.
Moore saw parallels to the theories covered in her previous psychology courses.
“You watch what the slime mold does under different variables, and suddenly the theories come alive. Game theory, self-interest, adaptation. It becomes practical, not abstract.”
Meanwhile, at the Blong Technology Center, Digital Modeling Instructor Brad McConnell received an email from Buckley.
Could his students design 3D mazes for the slime mold study?
McConnell said yes.
He handed the project to one of his most advanced students, Sam Leineke, who worked nights at Liberty Pattern and still came in after hours to model and print prototypes.
“It took three or four design iterations,” McConnell said. “It had to fit inside a five-inch Petri dish, be about an eighth-inch tall, and still be climbable for something with no feet.”
Fourteen mazes were printed on a Stratasys 3D printer and delivered to the microbiology lab. The slime mold explored them in ways that were sometimes methodical and sometimes unpredictable.
And, somewhere between salt barriers and printed mazes, a deeper question emerged: What does it mean for a brainless organism to behave as though it remembers, prefers, or decides.
Students compared its patterns to human ones, including stress, avoidance, perseverance, and persuasion. They joked about “depressed” or “stressed” slime mold that refused to move until a more adaptable neighbor fused with it.
For Carr, the political science
implications were unmistakable. “Ingroup/out-group behavior, resource allocation, cooperation — slime mold does all of it. It forces you to rethink what intelligence means.”
Students who once saw themselves as “not science people” became investigators with real data, real findings, and real confidence.
“Students who would’ve never stepped foot in a lab earned Honors credit,” Buckley said. “And truly, that fulfills our college’s mission.”
“What amazed me most,” Moore said, “was how excited everyone got. The spirit was contagious.”
Buckley and Carr have no plans to slow down. More classes will take up the study. More interdisciplinary collaborations are forming. Planaria, known for their regenerative abilities, are next.
“We’re going to keep pushing,” Buckley said. “I think we can program cells. I really do.”
This study is not famous. There are no million-dollar grants attached. Yet it achieved something important. It turned the Scott campus into a place where science is lived, not memorized. Where disciplines cross freely. Where students learn to trust their curiosity.
As Buckley recalls, one student leaned over a dish during the first week and whispered, “I can’t believe I’m actually doing science.” She was not alone. Over the course of the study, students watched slime mold stretch, adapt, retreat, and advance. In those slow movements, they recognized something familiar.

Curiosity. Persistence. The ability to try again.
For many, that recognition changed what they believed they were capable of. And in that way, this small, bright organism did exactly what science should do. It opened a door. It invited questions. It gave students a place to begin.
A reminder that the smallest beginnings can become something so much more. See the slime mold in action at eicc.edu/slime ⊲





























Jonathan Huddleston did not come to EICC looking for a fresh start. He came with experience, direction, and a clear reason for being here.
A U.S. Marine veteran, Huddleston spent more than 20 years working in the oil field, managing projects across Africa, the Middle East, Russia, the Mediterranean, the North Sea, and Latin America. His career took him around the world before bringing him to Muscatine.
After a heart attack and medical reevaluation through the VA, Huddleston was encouraged to find part-time work and consider returning to school as part of his long-term health plan. At 47, he enrolled in the Agribusiness Management AAS program at the Muscatine campus.
“It was a little intimidating coming back at my age and sitting next to students younger than my kids,” he said. “But the drive was there. I wanted to do something that mattered to me.”
That decision came with real financial considerations. Huddleston receives VA benefits, but those benefits do not cover the full cost of being a student. Iowa’s Last-Dollar Scholarship helped bridge the gap.















“The VA only covers so much,” he said. “I still have expenses like printer ink, paper, supplies, rent, electricity, everyday life. Every little bit helps.”
For Huddleston, the scholarship was not a bonus. It was practical support that allows him to stay enrolled while balancing coursework, part-time work, medical appointments, and family responsibilities.
He chose Agribusiness Management with intention.
Agriculture has been part of his life since childhood. His grandparents raised dairy and beef cattle. His children showed livestock.
Huddleston has a long-term plan to build a small, sustainable cattle operation focused on quality genetics and responsible management.
“I want to do this the right way. I’m not interested in the commercial side. I want to know my animals, understand the genetics, and build something sustainable,” he said.
The program covers business fundamentals and applied science, and students can complete up to three paid internships. Huddleston’s internship with Nutrien Ag Solutions has given him hands-on experience in fertilizer, chemistry, and crop inputs, areas he said genuinely interest him.
“It’s not about titles anymore. It’s about getting up, doing the work, and building something that fits where I’m at in life,” he said.
While at EICC, Huddleston also navigated the loss of his father to pancreatic cancer. He credits faculty and staff with helping him stay on track during extended absences while holding him to clear expectations.
When he graduates at 49, Huddleston will do so with a high GPA, a defined plan, and a degree that represents more than a credential.
“I told my dad I was going to do this before he got sick,” he said. “He told me, ‘Kick ass and do it.’ So I am.”
For Huddleston, the value of financial support is simple. It does not remove obstacles. It helps him move through them.
“I’m grateful for any assistance,” he said. “Because it helps with everyday life. And without that, it’s a lot harder to keep going.”
Learn more about the Last-Dollar Scholarship at eicc.edu/lastdollar ⊲




























































Six months into the job, Chancellor Bryan Renfro, PhD, is listening closely, showing up often, and shaping what comes next at EICC

















It’s early fall, and turkey feathers sway across campus.
Heads turn. Someone laughs. This is not an ordinary turkey sighting.










Inside the suit is Bryan Renfro, chancellor of EICC. Just a few months into the job and he’s costumed and visiting each campus, peppering students, faculty, and staff with fun questions, stopping for quick conversations and a few shared laughs.
“If you can make someone laugh, it makes it easier to have a real conversation,” Renfro said.
He laughs easily, like someone who doesn’t take himself too seriously — right up until the conversation turns to students. Then the humor stays, but the focus sharpens.

Friends and colleagues, he said, tend to land on one word: driven.







“They would definitely say that I’m driven, primarily on student success,” he said. “I don’t necessarily see that. I just do what I do because I’m passionate about it.”
That passion didn’t begin in an administrative office. It started in a classroom.
Renfro was a graduate student studying archaeology and anthropology at the University of Arkansas when a friend called with an offer.
“He said, ‘Hey, would you come teach an anthropology class at the community college? It pays $1,200.’ And I said, ‘I’m in,’” Renfro laughed.
The students who filled his night class weren’t traditional undergraduates. They arrived after work, carrying responsibilities that didn’t end when class began.
“They had families. They had jobs,” Renfro said. “They were really working to advance their lives and I just kind of fell in love with that. I fell in love with the students and with the mission of the community college.”
Renfro is in his second career.


The first — as an anthropologist and archaeologist — took him far from campus. He spent time in the Middle East, returning year after year to do archaeological and cultural anthropology work. He learned Arabic along the way, by listening closely and paying attention.
It’s a habit he’s retained.
“Cultural anthropologists study cultures,” he said. “Now, my culture is the community college and the students who go here.”
That perspective carries into how he talks about students. He sees them arrive with different backgrounds, different pressures, and different levels of doubt. What they share are hopes, dreams, and resolve.
“They want to get better,” Renfro said. “Sometimes they don’t even know what they want to be better at yet. They just know they want a better way of life.”
Those individual stories, he said, add up. Together, they shape how he understands the college as a whole. What he sees is a foundation already in place across a district united by a
shared mission.
“You don’t get to where this college is without people who care. That’s clear wherever you go,” he said.
Renfro has watched that care show up daily in classrooms, offices, and hallways, often quietly and without fanfare. “You earn that reputation through action,” he said. “Through teaching, supporting, advising, helping, and sometimes performing some small miracles before 9 a.m.”
It’s the kind of work Renfro talks about with respect, not rhetoric. Not something to replace, but something to support and strengthen.
That kind of progress doesn’t happen quickly. It takes collaboration, steady listening, and a willingness to keep asking questions. The posture of an anthropologist remains.
Again and again, he comes back to the same idea.
“We get better by staying focused on what matters most,” Renfro said. “That’s our students.”
The Aspen Institute has named EICC one of 200 institutions eligible to compete for the $1 million Aspen Prize for Community College Excellence. Only 20% of community colleges in the nation were invited to apply and compete for the prize.
Chosen from nearly 1,000 colleges nationwide, the Aspen 200 recognizes strong outcomes in student success, including persistence, completion, transfer, and workforce preparation. Colleges named to the list are invited to compete for the Aspen Prize for Community College Excellence, the nation’s top honor for community colleges.
While EICC did not advance to the next round of the Aspen Prize competition, “being named to the Aspen 200 is a real honor and a point of pride,” said Chancellor Bryan Renfro, PhD. “It reflects the care and effort people bring to their work every day, and it pushes us to keep raising the bar for our students.”






























Chris Bolin’s days are built around time blocks. Class. Lab. Work. Team meetings. Study. Repeat.

“Most of my days revolve around class,” he said. “I’m taking 17 credit hours, five classes. I work three parttime jobs, and I’m also on the Formula SAE race team.”




That schedule defines his life at the Milwaukee School of Engineering (MSOE), where Bolin is pursuing a bachelor’s degree in electrical engineering. It also explains why very little about his day feels optional.


Tests are short and frequent. Assignments stack. Formula SAE meets four to five times a week. Messages from teammates and professors come in daily. There is always something next.
Bolin describes it as “chaotic,” but not in a way that sounds unmanageable. More like tightly packed.


The academic pace is faster than what he experienced at EICC, but










Even when I’m overwhelmed, I can push through it. There’s nothing I can’t overcome at this point.


the workload itself is familiar. Before transferring, Bolin earned two degrees at EICC. During his final year, he intentionally increased the difficulty of his schedule, taking heavier course loads to better understand what university-level expectations would require.



“My experience at EICC helped prepare me because some of the subjects I’m learning now aren’t brand new. They’re just evolving,” Bolin said. That preparation becomes clear when he talks about engineering. At the Scott campus, his coursework emphasized application. Building systems. Troubleshooting. Working with equipment.


days on campus. Consistent routines. Using available support systems. TRIO played a role, not as a rescue, but as a place where being present and engaged was expected.
“Being in TRIO and spending time on campus really prepared me for this college,” he said. “That’s a lot of what I do now.”


At MSOE, the work has shifted toward theory, math, and design. “The tech degree at EICC prepares you to build. Now I’m learning how to design,” Bolin said.
That distinction matters most in Formula SAE, where students are responsible for bringing a hybrid race car back to operational status for the first time in years. The electrical system has not run since 2019. The team’s goal is to get every subsystem functioning together.




Bolin learned how to stay with difficult material instead of stepping away. How to ask questions early. How to keep working even when progress feels slow. Those habits mattered when his coursework became more abstract and more demanding.
During his final year at EICC, Bolin deliberately ramped up his course load again.


“It set the right expectations for how much time and work these classes take,” he said.
That decision made the transition to MSOE more predictable. Not easier, but predictable.
Outside class, Bolin was intentional about building a life that could support the workload. When he moved to Milwaukee, he knew no one. He also knew isolation would make everything harder.

Bolin works on the high-voltage side of the car. The work is collaborative and technical. Problems are worked through collectively, often over multiple meetings. Progress happens in pieces. When something does not work, the team stays with it.


He talks about Formula SAE the same way he talks about his classes: as another environment that demands preparation, communication, and patience.
Those habits did not appear by accident.



“It was important for me to get engaged,” he said. “I built community through work, through the Formula SAE team, and outside of school.”
Bolin transferred two jobs from Iowa and picked up another on campus. He chose housing close enough to make long days manageable. He also made sure his recovery community was in place before the semester began.

When Bolin returned to college, it followed a period of addiction that disrupted much of his earlier life. He acknowledges that period without elaboration. What matters more, he says, is what he built afterward.


At EICC, that meant structure. Long


Sobriety is not something he treats as separate from his academic life. It is part of the infrastructure that allows the rest of his schedule to function.
“This was another milestone. Even when I’m overwhelmed, I can push through it. There’s nothing I can’t overcome at this point,” Bolin said.
That does not mean his days are easy. They are full. Math-heavy. Time-



sensitive. But they are workable.
On some days, Bolin steps into a different role. As a transfer ambassador at MSOE, he leads campus tours for prospective students, many of whom are transfers themselves. He approaches those conversations without a script.



“I’m not a recruiter,” he said. “I just try to be transparent.”
He talks about workload. About expectations. About how different institutions serve different goals. Bolin asks students what they want out of college and explains why MSOE aligned with his priorities. Then he lets them decide what fits theirs.



That approach mirrors how he has moved through his own education. EICC was not a fallback. It was where he learned how to handle pressure and manage his time. MSOE is where he is applying those skills at a higher level.
Looking ahead, Bolin does not describe a single end point. Electrical engineering opens multiple paths, and he is still learning which one interests him most. Internships, like the one he’ll complete at Eaton this summer, will provide some clarity. Continued work with Formula SAE will too.



For now, his focus remains practical. Keep the schedule working. Stay engaged. Do the work.
Where Bolin is now did not come from one defining moment. It came from preparation layered over time — from learning how to build routines that hold up when the work gets heavy.


It is not dramatic.
It is steady. And it works.




From practical experience to four-year success, Bolin’s story shows what an EICC start can make possible. Learn more at eicc.edu/programs. ⊲


If you’ve ever wandered through Bickelhaupt Arboretum, you know the feeling: a moment of quiet awe, sunlight streaming through branches, a child squealing as they roll down a hill.
The Arboretum has long been a place where time slows and curiosity sparks. Soon, that sense of wonder will grow even deeper.
This spring, after more than two years of planning, design, and construction, EICC will unveil the most significant transformation in the Arboretum’s 70-year history.
“We’ve been entrusted with something extraordinary,” said Ann Eisenman, director of Clinton Community Colleges’ Paul B. Sharar Foundation. “This is about honoring the Bickelhaupt family’s vision while giving future generations even more reasons to fall in love with this place.”
Maintaining a living museum of more than 700 trees, shrubs, and collections of specialty plants is no small task. As needs grew, EICC began exploring how to sustain the Arboretum long-term.
In 2021, Shive-Hattery found it would be feasible to turn the
9,000-square-foot former homestead — including its large indoor pool room — into a revenue-generating education and event space.
A $4.5 million fundraising goal gained quick momentum thanks to donations from businesses, organizations, and individuals, along with grant support — pushing the total past $5 million. “It doesn’t matter if the gift was five dollars or a million,” Eisenman said. “Every single donor is now part of this Arboretum’s story.”
In August 2024, Studio 483, Clinton Engineering, and JT Construction kicked off the project. The transformation will be unveiled this spring and it starts with new, sustainable landscape features.
A $214,500 grant from the Iowa Department of Agriculture and Land Stewardship supported the addition of permeable paver walkway and parking lot, and a bioretention cell that will manage stormwater, protect the watershed, and serve as a living educational display.
“It will be filled with native Iowa plantings. It’ll be beautiful, functional, and a lesson in water conservation,” Eisenman said.
Inside, the Arboretum’s taxidermy collection — more than 70 animals, including a bear, bobcat, and snowy owl — will be on display within a walkthrough animal experience. Habitat scenes designed by McCullough Creative and immersive murals by local artist Gabi Torres, will transport visitors into Iowa’s native environments.
Just steps away, an entirely different kind of wonder will unfold. The Arboretum’s original kidney-shaped indoor pool will be the foundation for a blown-glass installation created by Joel and Logan Ryser of Hot Glass Inc., in Davenport.
Nearly 800-square-feet of illuminated glass will glow beneath a glass-tile floor. Eisenman said it will be an engineering and artistic marvel unlike anything else in the region. “When the lights hit the glass, it’ll be breathtaking,” she said. “This is pure artistry.”
And then … there’s the troll.
As part of an international installation series, Danish artist Thomas Dambo is creating one of his signature giant trolls for the Arboretum. The troll’s head will be
Pictured: One of Thomas Dambo’s giant trolls, “Marit” of the installation “It Sounded Like a Mountain Fell,” Wulong, China (2019).

crafted in Denmark from recycled materials and shipped to Clinton, where his team will assemble the body onsite using locally reclaimed wood.
Another troll will be installed at Clinton’s Sawmill Museum, creating a community-wide attraction. Dambo’s trolls draw global audiences: 69,000 out-of-town visitors in two months in one Wisconsin community alone.
“We’d be thrilled with even 10% of that,” Eisenman said with a laugh. “But truly, this is about joy, imagination, and exploration. It brings people together.”
As the project nears completion, a new associate director has joined the Arboretum team to build a schedule
of classes, workshops, performances, and community events.
“He understands meaningful programming,” Eisenman said. “Yes, we need to generate revenue, but education remains at the heart of everything. That balance is what will make the Arboretum thrive.”
A public ribbon cutting will be held in early May and will correspond to the installation of the trolls.
Eisenman admits this has been a big project. Timelines shift. Installations are intricate. Winter weather is never predictable. But gratitude outweighs every challenge.
In the mid-1950s, Bob and Frances Bickelhaupt settled into their Clinton home on 15 acres of rolling land, then witnessed Dutch elm disease decimate the area’s trees.
Inspired to take action, Bob and Frances Bickelhaupt, with guidance from horticulturists across the country, built what has become a nationally recognized outdoor museum of woody plants.
In 1970, the couple opened the Arboretum to the public and welcomed visitors from dawn to dusk, 365 days a year.
In 2000, their daughter Francie Hill returned to Clinton to serve as Arboretum director. She expanded educational and signature programming, including “No Child Left Inside,” which invited every K – 3rd grade student in Clinton County to enjoy some hands-on learning in nature.
“We have incredible partners, artists, engineers, and donors,” she said. “Every time I walk through the building and grounds, even in its dusty state, I think, ‘this is going to be more than we ever dreamed.’”
Scan here or visit eicc.edu/bickelhaupt to learn more about rentals, programming, and the upcoming ribbon cutting! ⊲
In 2014, after the Bickelhaupt couple had passed away, their family donated the Arboretum to the Paul B. Sharar Foundation and EICC.
Longtime Clinton Community College President Karen Vickers, PhD, worked closely with Hill and her daughter, Shawn Hill-Lamb, to finalize the gift, cementing a lasting legacy for the Bickelhaupt family and the community.
“Dr. Vickers, Francie, and Shawn were key voices in ensuring this extraordinary place would continue to flourish,” said Ann Eisenman, director of the Paul B. Sharar Foundation. “Their belief in EICC’s stewardship made everything that followed possible.”






Emersyn Keefer knows where everything is in the kitchen. The knives. The ovens. The rhythm of a class settling in. She should — she learned it here.


Long before she was hired to teach for EICC, she stood on the other side of the counter, a high school student earning college credit, learning how to work with precision and confidence.
Now, Keefer is the instructor, guiding students through the same fundamentals that shaped her, and proving that when opportunity starts early, it sticks.


Her entry into culinary arts was not planned. As a junior in high school, she was placed into a Fundamentals of Baking class without much expectation. By the end of the semester, that changed.
“I could see myself doing this for the rest of my life and actually enjoying my job,” Keefer said.

The difference was the work. It was daily, hands-on, and demanding. Cooking happened every class period. Progress was visible. The learning felt real.
That class also carried college
credit, an early signal that what Keefer was doing mattered beyond high school. When her instructor moved to teach at EICC, she followed, enrolling in the Culinary Arts Career Academy her senior year.
The academy accelerated everything. Her cohort was small — four students total — which meant constant engagement and accountability. Everyone showed up because they wanted to be there.
One moment stood out. She passed the ServSafe exam on her first attempt, the only student in her class to do so.

“That was the point where I thought, I can do this,” Keefer said.
From there, the focus deepened. Students learned core techniques — sauces, soups, proteins, eggs, sanitation — not as isolated tasks, but as skills meant to carry forward.
“The sauces and soups were the most valuable,” she said. “You can take that and put it into any dish.”
As graduation approached, Keefer considered other culinary schools. Several were options. Staying close to home was part of the equation, but it




Pictured: Emersyn Keefer prepares a dish during filming of “The College Tour” video series, 2023. The series followed ten student stories, including Keefer’s experience in EICC’s Culinary Career Academy.











I want them to walk into a kitchen and make a meal out of whatever they have. I want them to enjoy cooking.
was not the deciding factor.
What kept her was the environment she had already experienced — one built on consistency, mentorship, and shared expectations.


“It was the community,” she said. “Everybody was community-driven.”
After graduating high school in May 2023, Keefer continued her education, earning her culinary arts associate degree in spring 2025. Weeks later, a former instructor suggested she apply for an open teaching position.


demonstrate techniques, explain decisions, and guide students through the work. That approach became her model.

“At first, I applied thinking nothing of it,” she said. “I just wanted to see what would happen.”
What happened was fast. A demonstration. Interviews. Then an offer — delivered while she was returning from a trip to Alaska.
“I was ecstatic,” Keefer said. “And very nervous. It suddenly became real.”
She was hired in July 2025 and stepped into the same kitchens where she once trained.
Teaching without a traditional education degree felt unfamiliar at first, but not unmanageable. She had spent years observing instructors

“I never would have said this is where I would be,” Keefer said.

“They would demonstrate before we did anything. That is how I teach now,” Keefer said.
Her classes are structured but flexible. There is a framework, but no script. She plans week by week, and invites student input.

“I always ask for feedback,” Keefer said. “Did you like this? Would you do it again?”
She begins each class with a question of the day, a routine that gets students talking before they cook. When she skips it, they notice.
Keefer’s students range from high school juniors to adults with years of work experience. The age difference concerned her at first, but it hasn’t been an issue.
“They treat me with so much respect,” she said.
She teaches sanitation and safety, food fundamentals, and basic food preparation, with baking and hospitality math coming next semester.
Beyond technique, she wants students to leave with confidence in their cooking and ability to solve problems.


“I want them to walk into a kitchen and make a meal out of whatever they have. I want them to enjoy cooking and not see it as a chore,” she said.
That mindset extends beyond the classroom. She remains involved in community-based culinary work, including Taste Buds, a monthly program that brings special education students to campus to cook alongside chefs and students.

“I fell in love with it. It is one of my favorite things we do,” she said.
For now, Keefer is focused on building strong semesters, steady routines, and trust with her students.
She knows the space. She knows the work. She knows what it feels like to stand at the counter for the first time. And Keefer knows what comes next, because she has lived it — step by step, right here.

How one instructor’s 2,552-mile paddle reshaped the way he sees the world — and the way he shows up for his students.
When Shawn Hamerlinck decided to kayak the Mississippi River from Minnesota to the Gulf of Mexico this past summer, it wasn’t about reinvention. It wasn’t about proving anything. A long-held dream had finally ripened into a choice: you go, or you don’t.
Only about 30 people set off on this same source-to-sea trip each year. Typically, fewer than six finish. People wished him luck. Some urged caution. Many called it an ambitious “attempt.”
Hamerlinck, an EICC government instructor, spent 11 months training because he didn’t plan to attempt the trip. He planned to finish.
When people asked, “Who’s going with you?” Hamerlinck never changed his answer. “God. If God’s with me, who else do I need?”
He launched his kayak from the Mississippi’s headwaters at Lake Itasca, where the river is narrow, cold, and easy to wade across. On that first morning, a father and two teens started the same trip but quit by day two. As Hamerlinck paddled away, they stood on a small bridge and called, “Godspeed!” That was the moment reality set in.
“It was just me,” he said. “And it’s 31 degrees outside.”
That northern stretch wasn’t emotional isolation so much as uninterrupted time; the kind modern life rarely allows. With no cell service, the electronic detox began immediately. A cultural detox followed. “You’ve got days at a time with nothing to do but think,” he said.

Hamerlinck prayed often, sometimes to sort through decisions, sometimes because the quiet created space for it. The stillness sharpened what surrounded him: geese arguing, shifting clouds, tree lines bending over the water.
“You start noticing things you’ve never noticed,” he said. “It’s like watching the greatest live, all-natural television right in front of you.”
The Mississippi offered every kind of test — weather, wind, hours of paddling, and moments that demanded faith or instinct over analysis.
North of St. Louis, drifting toward the Chain of Rocks, he heard barge captains shouting over the radio, “He’s going in sideways.” Hamerlinck had been admiring the historic limestone towers when a familiar nudge urged him to turn. He saw he was seconds from disaster. His kayak shot straight down the six-foot drop; somehow, he was all right.
There were storms, soaked gear, and the morning in Arkansas when he realized wild boars had moved in behind him. “There were times I felt lonely,” Hamerlinck said. “But I never felt alone.”
His sharpest moment of clarity came not in danger, but in frustration — lost in the rain, cold, and yelling that he didn’t know which way to go.
“Then I heard, clear as day, ‘The river only goes one direction.’ The answer was right in front of me. I just wasn’t listening,” Hamerlinck said.
Fifty-five days after launching, he reached the Gulf of Mexico. The final push — 46 miles in rising water and the tailspin of Tropical Storm Dexter — took everything he had. The last four miles alone took eight hours. He finished exhausted, dozens of pounds lighter, and marked by the experience in a way he didn’t expect.

A man at Burns Point looked him over and said, “You’re the first one to make it in five years.”
But for Hamerlinck, the real challenge started when he got home.
After weeks wrapped in quiet, reflection, and scale, daily life felt loud. The urgency he once felt — in news cycles, in politics, in small frustrations — loosened. “You experience something like that and realize how small most problems are,” Hamerlinck said.

Pictured above: Shawn Hamerlinck at the Mississippi River headwaters, Itasca State Park, Minnesota.
Hamerlinck didn’t take the trip to become a better teacher. But he returned as one.
He teaches the same material with the same academic expectations, but he listens differently. He carries a broader sense of perspective. When students talk through worries that feel enormous — relationships, deadlines, setbacks — he understands how easy it is to mistake a moment for the whole story.
Hamerlinck doesn’t preach his river experience. He doesn’t use it as a lesson. But its presence is unmistakable.
He encourages students to trust their own capacity, to try the thing that scares them, and to understand that clarity often comes only after moving through something difficult or beautiful, or both.

Hamerlinck never tells them to paddle a river. He simply knows they’ll learn certain truths only after they’ve lived enough life to see them for themselves.
As he puts it, “They have to experience it.”



Artificial intelligence (AI) is no longer a future concept.
It is already shaping how businesses analyze data, automate work, and make decisions. EICC is responding with a new AI Programming degree to prepare graduates for entry-level roles in this growing field.
The two-year Associate of Applied Science degree is targeted to begin in fall 2026. The program will offer hands-on training in programming, data analysis, machine learning, and automation, giving students an entry point into AI careers.
Raine Morford, EICC’s Information Systems program director, said AI skills are increasingly expected in a wide range of jobs, but the training pathways have not always been clear or accessible. “This degree creates a practical way for students to build those skills and apply them in real work environments,” she said.
The new program responds to

growing employer demand for professionals who can support AI systems without requiring a four-year degree. While AI is often associated with research or advanced roles, many organizations need employees who can work with existing tools, manage data, and help integrate AI into daily operations.
“There is a gap between traditional IT programs and the skills employers are asking for right now. This degree bridges that gap by combining programming, data, and applied AI in a way that directly reflects how the technology is used on the job,” Morford said.
The program will be guided by a workforce advisory board. Members will review curriculum, offer feedback, identify emerging skills, and ensure the program remains aligned with a rapidly changing field.
“Artificial intelligence is evolving quickly, and our programs have to evolve with it,” Morford said.
“Employer input helps us stay responsive while giving students skills they can use immediately and build on over time.”
Two-year AI programs remain limited in Iowa. By adding this degree, EICC is offering advanced technology training closer to home while strengthening the regional workforce.
Information sessions are planned for later this spring and will provide an overview of the program, career pathways, and how these skills apply across a wide range of industries.
“AI is not out of reach. This program gives students a way to build meaningful, future-focused careers right here in their own communities,” Morford added. Learn more at

Riverbend FAME pairs employer leadership with EICC training to meet real workforce demand.
The need was evident long before the solution took shape. Manufacturers across Eastern Iowa struggled to fill industrial maintenance roles as retirements accelerated, and technology advanced.

reviewed the Industrial Maintenance curriculum taught at EICC’s Blong Technology Center and shaped it around real operational needs.


Positions stayed open. Production slowed. Employers raised the same concern again and again.
“Workforce development consistently rises to the top of conversations with employers,” said Chris Caves of Grow Quad Cities. Regional job data confirmed industrial maintenance ranks among the most critical high-skill, high-demand roles in local manufacturing.
“These are essential jobs,” Caves said. “They are positions that keep operations running and businesses competitive.”
As those conversations deepened, EICC joined the table, meeting with employers and workforce partners to examine how existing pathways could meet real demand.
The group didn’t look for a quick fix. They looked for a model that worked.


“The curriculum is not just helpful, it’s necessary,” said Shannon Johnson of SSAB, president of the Riverbend FAME chapter. “It reflects the real skills modern manufacturing requires.”
From an employer standpoint, the model builds momentum fast.
“Manufacturers across our region face the same challenge: finding skilled, dependable talent and building a pipeline for the long term,” Johnson said. “Students finish the program with thousands of hours of on-the-job experience and the confidence that comes from doing the work, not just studying it.”
National FAME partners describe the model as one built on relevance. Students “go to school and work at the same time,” learning in context and applying skills immediately.
Renfro said EICC’s role is clear.

Riverbend FAME grew out of that process. The program marks Iowa’s first chapter of the Federation for Advanced Manufacturing Education and places students inside the workforce while they earn an Industrial Maintenance Technician, Associate in Applied Science degree.

The structure changes the sequence. Students don’t train first and apply later. They start work immediately. Sponsoring employers hire them on day one, pay them, and rotate them between the manufacturing floor and the classroom over two years.



“Serving as the educational provider means listening closely to industry and responding with purpose,” he said. “This partnership reflects trust - between employers, educators, and students.”
Riverbend FAME didn’t arrive as a single organization’s idea. Employers named the problem. Partners shaped the response. Students will carry it forward.



For EICC Chancellor Bryan Renfro, PhD, the model answers a persistent question.

“Students want to know why what they are learning matters, and employers want to see skills translate quickly into performance,” he said. “Riverbend FAME makes learning immediate, applied, and connected.”





That connection depends on alignment. Employers








Riverbend FAME is a two-year, earn-and-learn program in Industrial Maintenance Tech. Students are hired by a sponsoring employer, earn a paycheck, and complete coursework at EICC.

EMPLOYERS:




How to Get Involved ⊲



Learn more at eicc.edu/fame.


Riverbend FAME is employer-led. Participating companies hire and mentor students and help shape their own long-term talent pipeline. Additional manufacturers can join Riverbend FAME.
Learn more at riverbendfame.com.


















April is Community College Month, and EICC is marking it the best way it knows how: by opening its doors.
Throughout April, EICC will offer more than 40 free, short-term classes and community events for the public. Anyone can sign up. No admission application. No tuition. No pressure.
“This is our way of saying thank you to everyone that supports us,” said Ashlee Spannagel, EdD, vice chancellor of workforce development. “Community colleges exist because of the community, and this gives us a chance to give something back.”
The classes are designed to be hands-on, practical, and accessible.
This year’s lineup will include options such as home fire safety, pet CPR and first aid, basic automotive maintenance, floral design, sweet and savory scones, book bingo, and car care. Classes will be taught by EICC instructors and staff across multiple campuses.
The goal is simple: create a low-risk way for people to step inside a college classroom and try something new.
“There is no commitment attached,” Spannagel said. “You can come in for one class, learn a skill, meet our instructors, and get a feel for what happens here.”
For some participants, the classes are purely for fun or personal growth. For others, they serve as a first look at programs and facilities they may not have considered before. Either way, the experience reflects what community colleges do best: practical learning, taught by experts, in spaces built for real-world skills.
The month also highlights the role EICC plays in workforce training, lifelong learning, and access to education. From recent high school graduates to adults looking to reskill or explore new interests, community colleges meet people where they are.
“EICC serves people at every stage of life,” Spannagel said. “This month is a reminder that learning can be approachable, affordable, and connected to real life.”
Details and registration information for April’s free classes and community events are available at eicc.edu/ freeclasses. Class offerings may vary by campus, and space will be limited.
Community College Month runs April 1 – 30. Mark your calendar now.
Scan here or visit eicc.edu/ccmonth to register! ⊲
We exist to give you first-class educational opportunities and do all we can to advance the local and state economy. We guarantee all people access to an affordable, high-quality education, whether you are seeking quick entry into the welding workforce or a two-year radiology degree.
DID YOU KNOW?
3 campuses + 10+ centers
Serving 7 counties
7,000+ students enrolled annually
5,000 HS students earning free college credit
Community College Month is coordinated by the Association of Community College Trustees (ACCT) to increase awareness of the many economic, academic, and equity advantages. EICC is proud to be among 1,000+ institutions across the U.S. celebrating Community College Month. Here’s why:
Community Colleges …
⊲ Provide higher education to students with the fewest resources and the greatest obstacles.
⊲ Are primary educators/ certifiers of in-demand nursing and other healthcare professionals.
⊲ Offer the most affordable, high-quality postsecondary education.
⊲ Are the most in-demand institutions during and following times of economic recession.
⊲ Serve the most demographically and socioeconomically diverse students.
⊲ Guarantee fair admissions to all students.
⊲ Are there for their communities in times of crisis.
(Source: acct.org)
200+ companies trained
18,000 continuing ed learners yearly
700+ faculty & staff





EICC summer camps give students ages 8 – 18 a reason to log off and lean in. Camps are handson, creative, and built around real interests, from 3D printing and media production to art, technology, and personal growth. Each camp keeps students creating, learning, and engaged.
New this year – funding is available on a first-come, first-served basis to help cover the cost of camp. Browse the full list of camps and register early! Less scrolling. More creating.
Camps run half days, with the option to stack select morning and afternoon camps for a full day. Students who stay all day can bring a sack lunch and drink and stay supervised by EICC staff during the lunch hour.